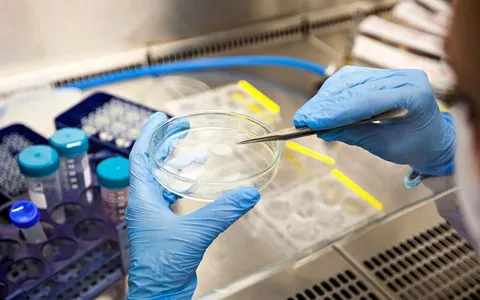

Let's try something today to instill a strange sense of pride in you for being engaged in business.
Ask people about anything, and you'll see them express their opinions.
For example, ask them about health, and you'll see them talk non-stop as if they are Professor Samii and Dr. Gharib and other dignitaries.

dental equipment and consumables
Similarly, when it comes to bodybuilding and fitness, a conversation will ensue as if an expert like Ronnie Coleman is sitting across from you.
When it comes to football, volleyball, and other sports, you feel like you're in the company of Ali Daei, Saeid Marouf, and others.
In discussions about art and cinema, you feel like you're facing Robert De Niro and Anthony Quinn.
When it comes to currency, dollars, and coins, they are the experts.
Regarding employment and labor, they are the ones with opinions.
Concerning money and the country's inflation situation, they are experienced analysts.
In political discussions, they criticize parties, rulers, and officials like experts.

In summary, they are eloquent speakers and experts in various fields.
But let's talk to them about business.
This is where you see most of them are silent and have no knowledge about it.
They may only say it's all about fraud, and merchants are dishonest, fueled by negative energies from movies and TV series, perhaps without having ever seen a real merchant or knowing what they do or how they make money.
Tell them how they can express opinions about something they have no knowledge of?
Thankfully, we Aradis have been placed in a position that most people are deprived of.
This blessing and superiority bestowed upon us require gratitude and praise.

In recent years, the occurrence of emergency incidents in dental offices has increased.
A dentist, as a member of the medical community, must be prepared in his/her clinic to save the lives of patients.
When elderly people and people with underlying diseases go to the dentist, medical emergencies may be needed.
What items does a dental emergency kit include? Stay with us to introduce it to you.
Advertisement for Purchasing Dental Equipment and Consumables
- Ad Type: Supply
- Ad Code: 21216
- Product Name: Dental equipment and consumables
- Buyer: Arad Branding for a Turkish merchant
- Order Volume: Based on supply and production levels in the country
- Payment Method: Cash on factory door
- Delivery Location: Factory door
- Types of Products: Attached file
- Required Information: Ad code, photo and video, price, telephone number, full name
- Contact Information: sale@aradbranding.com

0
0